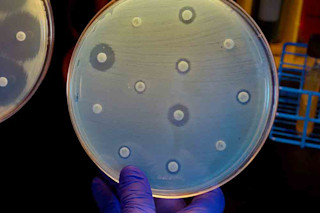

多年来,美国公共卫生官员一直在紧张地关注着耐药性超级细菌在全球蔓延,导致成千上万的人死亡。然后在1月份,美国疾病控制与预防中心的一份报告显示,内华达州一位老年妇女死于一种细菌感染,这种感染甚至连感染抵抗武器库中最强大的武器都无法抵抗。那时,许多美国专家敲响了警钟:阻止这些致命病原体的时间不多了。
明尼苏达大学医学和传染病教授詹姆斯·约翰逊说:“我们正处于完全恐慌和我们有信心能够控制的情况之间。” 仅在美国,超级细菌每年就夺走 23,000 名美国人的生命,并且在过去八年中,对抗生素具有耐药性的住院儿童人数增加了七倍。
在全球范围内,情况更加糟糕:每年有超过 70 万人死于耐药性感染,尤其是在欧洲、亚洲和南亚部分地区。 这些地区卫生条件不足,为致命病原体创造了滋生地——内华达州妇女在印度感染了致命的细菌。 一些专家警告说,由于人类和牲畜多年来使用抗生素而导致的新型耐药细菌菌株与寨卡病毒和埃博拉病毒一样令人担忧。 世界卫生组织确定了对人类构成最大威胁的十二组细菌。
约翰逊警告说,美国的情况可能会变得同样糟糕。 受感染的国际旅行者会加速超级细菌的传播,而且国内有大量易受感染的人群——体弱的老年人和免疫系统受损的人。 如果抗生素的效果降低,即使是阑尾切除术和剖腹产等常规手术也可能变得危险,并可能导致每年多达 6,300 人死亡。
尽管如此,美国的形势有所改善,这主要是由于医院里更强的警惕性和更好的感染控制技术,耐药细菌可能在医院里流行。 布鲁克林纽约州立大学下州医学中心的传染病专家约翰·奎尔说,“我们正在做得更好,因为人们现在已经足够害怕了。”
一些有希望的抗生素正在开发中,应该很快就可以使用,但没有一种被认为是灵丹妙药。 同时,约翰逊说,“我们需要找到让医生更好地管理抗生素的方法。”